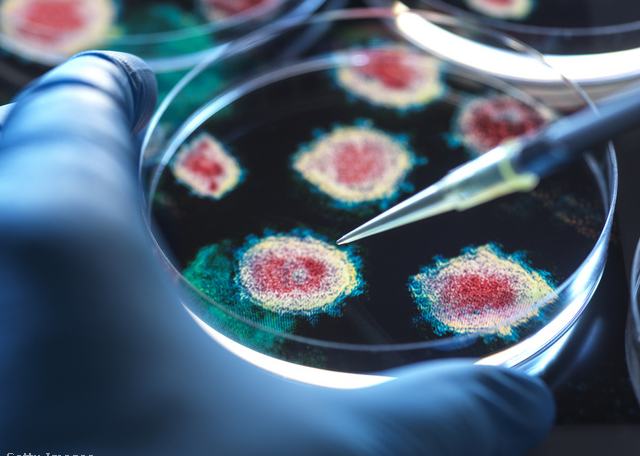

Több ezer sertést kell elaltatni várhatóan a Horvátországban terjedő kór, a sertéspestis miatt.
Amint arról az agroinform.hu beszámolt, David Vlajcic, Horvátország mezőgazdasági minisztere közölte, tízezer sertést kell majd elaltatniuk a sertéspestis miatt a bellyei (Belje) mezőgazdasági vállalat katalinpusztai (Sokolovac) telephelyén.
A tárcavezető hangsúlyozta, hogy az ország eddigi legnagyobb járványgócával állnak szemben.
A sertéspestist (ASP) ráadásul másutt, Eszék mellett is kimutatták egy nemetini telepen, ahol 1600 állatot érint a pusztító kór. Horvátországban 2023 óta 41 ezer állatot kellett elaltatni a betegség miatt.

Sertéspestis pusztít Horvátországban
A miniszter szerint
![]()
„A betegség terjedéséért kizárólag az emberi tényező, a felelőtlenség és az illegális tevékenységek okolhatók, a fő terjesztő tehát maga az ember."
A teljes horvát sertésállomány mintegy 5 százaléka veszett oda az elmúlt években a sertéspestis miatt. A tárcavezető arra is emlékeztetett, hogy a tartási körülmények okán − az állomány mintegy 67 százalékát az állattartó telepek 1,5 százalékán nevelik − fennáll a veszélye annak is, hogy a jelenlegi, 5 százalékos kiesés
![]()
akár 75 százalékosra emelkedhessen,
ha a sertéspestis a nagyobb gazdaságokra is átterjed. Ha nem lesznek elég határozottak a védekezésben, akár az EU-n belül is elszigetelődhetnek David Vlajcic szerint.
Ezért veszélyes kórság a sertéspestis
A sertéspestist még nyár közepén azonosították az Eszék-Baranya térségi vaddisznókban, és már akkor attól tartottak, hogy a betegség átterjed a házi sertésekre is. Az afrikai sertéspestis emberre nem veszélyes, így közegészségügyi kockázata sincs, azonban
![]()
a felelőtlen emberi magatartásnak szerepe van a vírus terjedésében.
Mivel sem védőoltás, sem gyógyszer nem áll rendelkezésre a kór ellen, ez azt jelenti, hogy a fertőzött állatokat, és a velük kapcsolatba került egyedeket is el kell altatni, a tartási helyet pedig fertőtleníteni kell.























